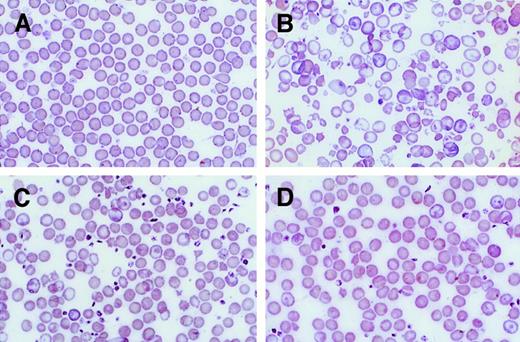
Fig. 2. PB smears of β-thalassemic/normal hematopoietic chimeras to demonstrate amplification of the genetically normal red cells. / (A) Wright-Giemsa–stained PB smear from an animal transplanted with genetically normal BM. (B) Smear from an animal transplanted with β-thalassemic BM. (C) Smear from a chimeric animal with 12% normal HSCs and 56% normal Hb in the PB. (D) Smear from a chimeric animal with 20% normal HSC engraftment and 81% normal Hb in the PB. Photomicrographs are at 250 × magnification.

Abstract
As initial human gene therapy trials for β-thalassemia are contemplated, 2 critical questions important to trial design and planning have emerged. First, what proportion of genetically corrected hematopoietic stem cells (HSCs) will be needed to achieve a therapeutic benefit? Second, what level of expression of a transferred globin gene will be required to improve β-thalassemic erythropoiesis? These questions were directly addressed by means of a murine model of severe β-thalassemia. Generation of β-thalassemic mice chimeric for a minority proportion of genetically normal HSCs demonstrated that normal HSC chimerism levels as low as 10% to 20% resulted in significant increases in hemoglobin (Hb) level and diminished extramedullary erythropoiesis. A large majority of the peripheral red cells in these mice were derived from the small minority of normal HSCs. In a separate set of independent experiments, β-thalassemic mice were bred with transgenic mice that expressed different levels of human globins. Human γ-globin messenger RNA (mRNA) expression at 7% of the level of total endogenous α-globin mRNA in thalassemic erythroid cells resulted in improved red cell morphology, a greater than 2-g/dL increase in Hb, and diminished reticulocytosis and extramedullary erythropoiesis. Furthermore, γ-globin mRNA expression at 13% resulted in a 3-g/dL increase in Hb and nearly complete correction of red cell morphology and other indices of inefficient erythropoiesis. These data indicate that a significant therapeutic benefit could be achieved with expression of a transferred globin gene at about 15% of the level of total α-globin mRNA in patients with severe β-thalassemia in whom 20% of erythroid precursors express the vector genome.
Introduction
Worldwide, β-thalassemia is one of the most common monogenic disorders in humans and accounts for significant morbidity and mortality.1-3 Severe β-thalassemia is characterized by markedly ineffective erythropoiesis and severe anemia, which usually necessitate lifelong red cell transfusions. Along with the already augmented iron absorption, transfusion therapy in patients with severe β-thalassemia can lead to progressive iron accumulation and tissue damage in multiple organs. In developed countries, most patients with severe β-thalassemia receive adequate transfusion to maintain good health along with iron chelation, which, when used regularly, prevents or retards iron-induced tissue damage.4 However, chronic transfusion support is complicated by suboptimal chelation compliance, high rates of allo-immunization, and blood-borne infectious sequelae.5-7Alternatively, allogeneic bone marrow (BM) transplantation is possible for those patients having suitable, available donors. But early mortality and chronic graft-versus-host disease are complications even for class 1 patients receiving HLA-matched sibling grafts.8-11 Thus, severe β-thalassemia remains a serious public health problem for which more effective treatment is clearly needed.
The biochemical defect in patients with β-thalassemia, namely deficient β-globin synthesis, has been known for more than 3 decades, and the many individual mutations that lead to the β-thalassemia phenotype have been catalogued.1,3 Therefore, there exists great potential for genetic correction of the thalassemia lesion via gene transfer into autologous hematopoietic repopulating cells. Fifteen years ago, this goal seemed attainable when onco-retroviral vector–mediated gene transfer into primitive murine stem cells was achieved.12,13 However, gene transfer into human stem cells has been much more difficult.14 Additionally, the ability to deliver a functional globin gene along with the regulatory elements necessary to achieve high-level globin gene expression in developing erythroblasts has been technically challenging.15-18 Recent progress on both fronts has finally created the possibility that gene therapy for β-thalassemia might be clinically tested within the next several years.19-24
As gene therapy trials for β-thalassemia are contemplated, a number of critical questions must first be considered. First, what is the proportion of corrected HSCs needed to improve the clinical phenotype? Even with improved vector systems, stem cell–targeted gene transfer is likely to be far below 100% efficiency and will result in a mixed population of transduced and nontransduced cells for transplantation. Furthermore, since autologous reconstitution with this mixed population of cells is likely to be attempted without myeloablation in order to reduce toxicity, surviving endogenous stem cells will further reduce the level of gene-corrected cells in a recipient. Because of ineffective erythropoiesis and shortened red cell survival, gene-corrected erythroid cells are likely to be preferentially amplified. The results of early transplantation studies in murine models of α- and β-thalassemia are consistent with this prediction.25-29 Also, rare patients with β-thalassemia have been reported who have undergone allogeneic transplantation and have stable chimerism with fewer than 50% donor leukocytes but nonetheless appear to have significant clinical improvement.30-33 However, the quantitative relationship between normal HSC chimerism and erythroid chimerism in β-thalassemic transplant recipients and the threshold level of normal chimerism required to effect clinical improvement have not been clearly defined.
The second critical issue relevant to the potential success of gene therapy for β-thalassemia is the level of expression of a transferred globin gene that is necessary to significantly improve red cell production and survival. It is known from genetic evidence that the severity of the thalassemia phenotype is generally proportional to the imbalance in globin chain synthesis.1,3 Co-inheritance of an α-thalassemia mutation in individuals with homozygous β-thalassemia, which reduces the ratio of α to non–α-globin synthesis, often leads to a thalassemia intermedia phenotype without the need for transfusion. Similarly, the level of fetal hemoglobin synthesis is also a major genetic modifier of the severity of homozygous β-thalassemia. Patients who are homozygous for β-thalassemia but who have a mutation/polymorphism that leads to increased γ-globin chain synthesis often have a mild clinical phenotype.1-3 Clearly, 50% of the normal level of β-globin synthesis is adequate for nearly normal erythropoiesis in individuals heterozygous for β-thalassemia, but genetic evidence suggests that significantly lower levels are also likely to be beneficial. Since the level of globin gene expression achieved by gene transfer is likely to be significantly lower than the output of one normal β-globin gene, quantitative data defining the required globin transgene expression levels will facilitate translating preclinical evaluations of globin vectors to the planning of clinical trials.
Animal models are available to address these critical questions. Mice with β-thalassemia due to either a naturally occurring deletion of the βmajor gene or removal of the β-globin gene locus by gene-knockout technology have been described and characterized.34-36 In the latter strains, animals homozygous for the knockout allele cannot be recovered; however, heterozygous animals are viable and have severe anemia, ineffective erythropoiesis, and massive extramedullary erythropoiesis. These animals most closely approximate patients with more severe forms of β-thalassemia intermedia. Here we report the use of these mice to generate a series of BM chimeras composed of varying proportions of genetically normal and β-thalassemic hematopoiesis. This allowed us to precisely determine the proportion of genetically normal HSCs required to improve the thalassemic phenotype. In addition, we have evaluated the effect of varying levels of human globin gene expression on the phenotype of β-thalassemic erythropoiesis by breeding thalassemic animals with mouse strains having human globin transgenes expressed at different levels.37-39 Together, these data should be beneficial to the planning of both future gene therapy trials and possible nonmyeloablative, allogeneic mini-transplant approaches to the treatment of β-thalassemia.
Materials and methods
Mouse strains
Heterozygous β-thalassemic mice were a gift from Dr T. Townes (University of Alabama at Birmingham)36 and were bred for more than 10 generations onto the C57BL/6J/HW80 background. Congenic C57BL/6J, C57BL/6J Ly 5.1 (B6.SJL-PtprcaPep3b/BoyJ), and HW80 mice (B6.C-TyrcH1b Hbbd/By) were obtained from Jackson Laboratories (Bar Harbor, ME). Mice expressing a human (h) γ-globin transgene driven by the β-spectrin37 or ankyrin promoter38 were bred with heterozygous β-thalassemic mice to produce thalassemic mice expressing hγ-globin. Additionally, thalassemic mice with the β-spectrin–hγ-globin transgene were interbred to obtain mice heterozygous for the thalassemic knockout allele and homozygous for the γ-globin transgene. C57/BL/6J mice heterozygous for an hβ-globin locus39 contained on a yeast artificial chromosome (provided by Drs Karin Gaensler [University of California, San Francisco] and John Cunningham [St Jude Children's Research Hospital, Memphis, TN]) were also bred with the β-thalassemic mice to generate mice containing the thalassemic knockout allele and expressing the hβ-globin gene. Transgenic mice were genotyped by means of a combination of DNA analysis (Southern blotting) and hemoglobin (Hb) electrophoresis.
Transplantation procedures
To generate animals chimeric for normal and β-thalassemic hematopoiesis, fresh BM cells were obtained from the hind limbs of female β-thalassemic donors (phenotype: “diffuse” Hb allele, characterized by distinct, separate mouse (m) α2mβmaj2 and mα2βmin2 bands upon Hb electrophoresis; Ly-5.2 allotype) and normal female Ly-5.1 donors (phenotype: “single” Hb alleles characterized by the mα2mβs2 and mα2mβt2 bands that run together upon Hb electrophoresis as one band that is distinct from the diffuse pattern36; Ly-5.1 allotype). We prepared a series of marrow cell mixtures consisting of from 5% to 50% genetically normal, Ly-5.1 nucleated cells. Separate cohorts of lethally irradiated (1100 cGy), age-matched, female HW80 animals were transplanted with cells of each mixture, with normal Ly-5.1 cells alone, and with β-thalassemic cells alone. Additionally, a cohort of animals chimeric for normal HW80 (diffuse Hb alleles; Ly-5.2 allotype) and normal Ly-5.1 hematopoiesis (single Hb alleles; Ly-5.1 allotype) were generated by transplanting a mixture composed of 30% Ly-5.1 cells with 70% HW80 cells. All animals received a total of 4 × 106 cells by tail vein injection.
Hematologic analysis
Blood samples were obtained by retro-orbital puncture of anesthetized chimeric mice 4 months post-transplantation and from anesthetized adult knockout, transgenic mice 2 to 4 months of age. An automated blood cell analyzer (Hemavet 3700; CDC Technologies, Oxford, CT) was used to obtain complete blood counts. Peripheral blood (PB) films were prepared by means of standard methods, and reticulocytes were enumerated on smears of cells stained with methylene blue. Hb cellulose acetate gel electrophoresis40 was performed as previously described,37 and an AlphaImager 2200 visualization system (Alpha Innotech, San Leandro, CA) was used to quantitate the Hb bands.
Hematopoietic chimerism determined by Southern blot analysis
PB leukocyte DNA was prepared by means of the PureGene DNA Isolation Kit (Gentra Systems, Minneapolis, MN) according to the manufacturer's specifications. Approximately 7.5 μg genomic DNA was digested with EcoRI and electrophoresed through 0.7% agarose. DNA was transferred to HyBond-N (Amersham Pharmacia Biotech, Piscataway, NJ) membranes and subsequently probed with a radiolabeled mβ-globin DNA probe (611-base pair [bp] PstI-BamHI IVS 2 fragment) that distinguishes the single Hb allele (βs and βt), yielding hybridizing bands of 10.3 and 10.7 kb, from the diffuse Hb allele (βmaj and βmin), which yields bands of 14.8 and 7.3 kb.41 A Molecular Dynamic (Sunnyvale, CA) Storm Phosphoimager was used to visualize and quantitate the resulting hybridizing bands.
Hematopoietic chimerism determined by fluorescence activated cell sorting analysis for the Ly-5 allo-antigen
PB samples were depleted of red cells by ammonium chloride lysis, and leukocytes were pelleted and washed with phosphate-buffered saline containing 2% fetal calf serum. Murine Fcγ receptors were blocked by means of an anti-CD16 antibody (Pharmingen, San Diego, CA) at a 1:50 dilution. Cells were then stained with a phycoerythrin (PE)–conjugated monoclonal antibody against CD45.1 (Ly-5.1) (Pharmingen) at a final dilution of 1:100. The lymphocyte and granulocyte populations, as defined by conventional light-scatter characteristics, were analyzed for the proportion of Ly-5.1+ cells by means of a FACSCalibur flow cytometer (Becton Dickinson, San Diego, CA). The percentage of lymphocytes and granulocytes derived from each component of the graft correlated well with each other, as others have previously observed.42 Hematopoietic stem cell (HSC) engraftment in the lethally irradiated recipients was estimated from the percentage of PB lymphocytes derived from a particular graft component. Where indicated, splenic and BM erythroid precursors were stained with a combination of a fluoroscein isothiocyanate–conjugated CD45.1 antibody (Ly-5.1) (Pharmingen) and a biotinylated TER119 antibody (Ly-76) (Pharmingen) at a final dilution of 1:100. A streptavidin-allophycocyanin (APC; Pharmingen) secondary reagent was used to detect cells staining with TER119.
Fluorescence activated cell sorting analysis of red blood cells for expression of human globins
We processed 5 to 10 μL blood as previously described to fix and permeabilize the red cells for subsequent antibody staining.43 Biotinylated monoclonal antibodies against hγ- and hβ-globin chains (Wallac, Akron, OH) were used to stain the permeabilized cells according to the manufacturer's specifications. A streptavidin-PE secondary reagent (Southern Biotechnology, Birmingham, AL) was used at a 1:200 dilution to detect cells staining with the primary antibodies. Red cells were gated on by light-scatter characteristics and analyzed for PE fluorescence by means of a FACSCalibur.
RNase protection assays
RNA was extracted from blood samples by means of RNazol B (Tel-Test; Friendswood, TX) according to the manufacturer's specifications. 32P-labeled riboprobes for mα-globin exon 1,44 hγ-globin exon 2,45 and hβ-globin exon 146 (which yield protected fragments of 128, 225, and 135 bp, respectively) were prepared by means of linear DNA templates and the Maxiscript in vitro transcription kit (Ambion, Austin, TX) according to the manufacturer's specifications. Preliminary experiments determined that when 250 ng RNA was used, all probes were in excess. Hybridization of probe and RNA samples was carried out overnight according to the standard procedure for the RPA II RNase protection assay kit (Ambion). RNase digestion was performed with an RNase A-RNase T1 mixture in RNase digestion buffer, and the protected fragments were separated on a 6% denaturing polyacrylamide gel (Gel-Mix 6; Life Technologies, Rockville, MD). A Molecular Dynamic Storm Phosphoimager and its accompanying software were used to visualize and quantitate the protected fragments. Quantitation of hγ- and hβ-globin messenger RNA (mRNA) levels relative to the total mα-globin mRNA level was derived by dividing the absolute value for the human globin–protected fragment by the value for the mα-globin–protected fragment and multiplying by a correction factor for the number of labeled residues present in the respective protected fragments. Assays were performed independently at least 2 times on 2 different mice for each specified strain, and the mean values for relative expression are reported.
Statistical methods
The probability of a statistically significant difference between the mean values of 2 data sets was determined by a 2-tailed Student t test with the use of Instat 2.03 software for Macintosh (Apple, Cupertino, CA).
Results
Amplification of the genetically normal erythroid component in animals chimeric for normal and β-thalassemic hematopoiesis
Lethally irradiated mice were transplanted with mixtures of congenic, genetically normal BM cells (characterized by the single Hb alleles and the Ly-5.1 allotype) and β-thalassemic BM cells (characterized by the diffuse Hb allele and the Ly-5.2 allotype) in ratios designed to yield chimeric animals with HSC engraftment ranging from 5% to 50% of normal. At 4 months following transplantation, fluorescence activated cell sorting (FACS) analysis of PB lymphocytes for the Ly-5 allotypic marker was used to determine the contribution of each of the 2 components of the BM graft to hematopoiesis in the animals (see “Materials and methods” and Mardiney and Malech42). The mixtures of cells infused into these animals contained 8.9%, 19.1%, 30.9%, and 47.5% of genetically normal BM cells, respectively, on the basis of cell counts. The resulting cohorts of animals had an average of approximately 10%, 20%, 30%, or 46% of normal stem cell engraftment (Figure1; Table1). These engraftment levels therefore tightly correlated with the percentages of normal BM cells contained in the infused grafts for each cohort. This established that normal and β-thalassemic HSCs have similar capacity for nonerythroid reconstitution in a competitive repopulation transplantation setting.
Amplification of the normal erythroid component in β-thalassemic/normal hematopoietic chimeras.
Cohorts of chimeric mice (group 2, n = 9; group 3, n = 11; group 4, n = 11; group 5, n = 6), characterized by a minority component of normal donor HSC engraftment (indicated by the open bars), demonstrated disproportionately large contributions to erythropoiesis from the genetically normal component of the graft as measured by the percentage of its contribution to total Hb in the PB (indicated by the black bars). Group 6 (n = 6) is a cohort of animals chimeric for 2 different distinguishable normal stem cell components; the data for this group represent the stem cell and erythroid contribution from the same donor cells that were used for the genetically normal component in groups 2 through 5. Data represent the mean values and SEM for each group of animals. Normal donor stem cell engraftment and normal donor Hb levels are significantly different from each other (P < .0001) in groups 2, 3, 4, and 5, but are not significantly different in group 6 (P = .11).
Amplification of the normal erythroid component in β-thalassemic/normal hematopoietic chimeras.
Cohorts of chimeric mice (group 2, n = 9; group 3, n = 11; group 4, n = 11; group 5, n = 6), characterized by a minority component of normal donor HSC engraftment (indicated by the open bars), demonstrated disproportionately large contributions to erythropoiesis from the genetically normal component of the graft as measured by the percentage of its contribution to total Hb in the PB (indicated by the black bars). Group 6 (n = 6) is a cohort of animals chimeric for 2 different distinguishable normal stem cell components; the data for this group represent the stem cell and erythroid contribution from the same donor cells that were used for the genetically normal component in groups 2 through 5. Data represent the mean values and SEM for each group of animals. Normal donor stem cell engraftment and normal donor Hb levels are significantly different from each other (P < .0001) in groups 2, 3, 4, and 5, but are not significantly different in group 6 (P = .11).
Effects of genetically normal HSC chimerism on erythropoiesis in β-thalassemic mice
| Group . | Normal HSC engraftment, % . | Hb, g/dL . | MCV, fL . | MCH, pg . | RDW . | Retic, % . | Spleen, mg . |
|---|---|---|---|---|---|---|---|
| 1 | 0 | 9.24 ± 0.27 | 40.7 ± 0.5 | 11.6 ± 0.1 | 29.6 ± 0.6 | 21.2 ± 1.7 | 242 ± 8 |
| 2 | 10.0 ± 1.4 | 10.3 ± 0.1* | 42.9 ± 0.1† | 12.8 ± 0.3* | 27.2 ± 0.7† | 17.8 ± 0.5 | 132 ± 8* |
| 3 | 19.9 ± 0.9 | 10.9 ± 0.1* | 43.8 ± 0.4† | 13.5 ± 0.2* | 25.1 ± 0.8† | 10.0 ± 1.3* | 118 ± 9* |
| 4 | 30.2 ± 0.8 | 11.2 ± 0.1* | 42.9 ± 0.4† | 13.6 ± 0.2* | 22.3 ± 0.3† | 5.2 ± 1.2* | 102 ± 4* |
| 5 | 46.2 ± 2.4 | 11.7 ± 0.3* | 43.2 ± 0.9† | 13.5 ± 0.4* | 22.3 ± 1.2† | 4.0 ± 0.7* | 101 ± 5* |
| 6 | 100 | 12.1 ± 0.1* | 43.2 ± 0.2† | 13.6 ± 0.4* | 18.8 ± 0.3† | 1.8 ± 0.2* | 95 ± 8* |
| NA | Non-Tx HW80 | 13.5 ± 0.1* | 43.5 ± 0.1† | 13.7 ± 0.1* | 18.0 ± 0.1† | — | — |
| Group . | Normal HSC engraftment, % . | Hb, g/dL . | MCV, fL . | MCH, pg . | RDW . | Retic, % . | Spleen, mg . |
|---|---|---|---|---|---|---|---|
| 1 | 0 | 9.24 ± 0.27 | 40.7 ± 0.5 | 11.6 ± 0.1 | 29.6 ± 0.6 | 21.2 ± 1.7 | 242 ± 8 |
| 2 | 10.0 ± 1.4 | 10.3 ± 0.1* | 42.9 ± 0.1† | 12.8 ± 0.3* | 27.2 ± 0.7† | 17.8 ± 0.5 | 132 ± 8* |
| 3 | 19.9 ± 0.9 | 10.9 ± 0.1* | 43.8 ± 0.4† | 13.5 ± 0.2* | 25.1 ± 0.8† | 10.0 ± 1.3* | 118 ± 9* |
| 4 | 30.2 ± 0.8 | 11.2 ± 0.1* | 42.9 ± 0.4† | 13.6 ± 0.2* | 22.3 ± 0.3† | 5.2 ± 1.2* | 102 ± 4* |
| 5 | 46.2 ± 2.4 | 11.7 ± 0.3* | 43.2 ± 0.9† | 13.5 ± 0.4* | 22.3 ± 1.2† | 4.0 ± 0.7* | 101 ± 5* |
| 6 | 100 | 12.1 ± 0.1* | 43.2 ± 0.2† | 13.6 ± 0.4* | 18.8 ± 0.3† | 1.8 ± 0.2* | 95 ± 8* |
| NA | Non-Tx HW80 | 13.5 ± 0.1* | 43.5 ± 0.1† | 13.7 ± 0.1* | 18.0 ± 0.1† | — | — |
Values represent the mean and SEM.
Non-TX indicates nontransplanted; Hb, hemoglobin; MCV, mean corpuscular volume; MCH, mean corpuscular hemoglobin; RDW, red cell distribution width; retic, reticulocyte; Spleen, splenic weight. Dashes indicate that the measurement was not done.
Statistically significant difference from group 1; P at least < .003.
Statistically significant difference from group 1; P at least < .025.
Hb electrophoresis was used to distinguish the single Hb, derived from the normal red cells, from diffuse Hb, which was derived from the thalassemic red cells. This allowed the contributions of the 2 components of the graft to erythropoiesis to be quantitatively determined (Figure 1). In each cohort, there was significant amplification (up to 5-fold) of the normal red cells as follows: lymphocytes 10% vs red cells 50% (group 2); lymphocytes 20% vs red cells 72% (group 3); lymphocytes 30% vs red cells 79% (group 4); and lymphocytes 46% vs red cells 84% (group 5). The percentage of normal donor Hb in the PB of the chimeric animals correlated with the proportion of morphologically normal red cells on PB films (Figure2). In contrast, control animals (group 6), which received a mixture of 2 normal BMs, each differing for the Ly-5 and Hb markers, had equivalent proportions of lymphocytes and red cells (24% and 27%, respectively) from the Ly-5.1 component, which composed 30% of the graft infused into these recipients (Figure 1). This confirmed the specificity of the red cell amplification in the β-thalassemic/normal hematopoietic chimeras. In a separate transplantation experiment that contained similar cohorts of chimeras, we used DNA analysis based on the 2 differing Hb alleles of the graft components (see “Materials and methods”), rather than flow cytometry, to quantitate the contribution of each graft component to the PB leukocyte population. These studies yielded red cell amplification and phenotypic correction results similar to those described above (data not shown).
PB smears of β-thalassemic/normal hematopoietic chimeras to demonstrate amplification of the genetically normal red cells.
(A) Wright-Giemsa–stained PB smear from an animal transplanted with genetically normal BM. (B) Smear from an animal transplanted with β-thalassemic BM. (C) Smear from a chimeric animal with 12% normal HSCs and 56% normal Hb in the PB. (D) Smear from a chimeric animal with 20% normal HSC engraftment and 81% normal Hb in the PB. Photomicrographs are at 250 × magnification.
PB smears of β-thalassemic/normal hematopoietic chimeras to demonstrate amplification of the genetically normal red cells.
(A) Wright-Giemsa–stained PB smear from an animal transplanted with genetically normal BM. (B) Smear from an animal transplanted with β-thalassemic BM. (C) Smear from a chimeric animal with 12% normal HSCs and 56% normal Hb in the PB. (D) Smear from a chimeric animal with 20% normal HSC engraftment and 81% normal Hb in the PB. Photomicrographs are at 250 × magnification.
Amelioration of the β-thalassemic phenotype by a minority population of genetically normal stem cells
Animals engrafted with an average of 10% (group 2) or 20% (group 3) of genetically normal HSCs exhibited significant correction of the β-thalassemic phenotype (Figures 2 and3; Table 1). The striking abnormalities in red cell morphology present in animals reconstituted with only thalassemic marrow (Figure 2B) were much less evident in animals having approximately 12% or 20% genetically normal HSC engraftment (Figure2C,D). Significant increases in Hb concentration, relative to animals reconstituted with only thalassemic marrow (group 1), were noted in animals with 10% (group 2) or 20% (group 3) of normal HSC chimerism (Figure 3; Table 1). Further incremental increases in Hb were noted in animals engrafted with 30% (group 4) or 46% (group 5) genetically normal HSCs.
The degree of correction of anemia in β-thalassemic/normal hematopoietic chimeras as a function of the level of genetically normal HSC engraftment.
The PB Hb concentration is shown for each of the groups of animals shown in Figure 1 that are characterized by the indicated level of genetically normal HSC engraftment: Group 1 (transplanted with β-thalassemic BM alone; n = 8), 0%; group 2, 10.0%; group 3, 19.9%; group 4, 30.2%; group 5, 46.2%; and group 6, 100%. Group 7 (n = 5) represents a cohort of mice transplanted with 100% genetically normal Ly-5.1 BM cells. The data represent the mean and SEM of Hb concentration for each group. Groups 2 through 7 all differ significantly in Hb from group 1 (Pat least < .003). Groups 5, 6, and 7 did not significantly differ from one another (P > .25).
The degree of correction of anemia in β-thalassemic/normal hematopoietic chimeras as a function of the level of genetically normal HSC engraftment.
The PB Hb concentration is shown for each of the groups of animals shown in Figure 1 that are characterized by the indicated level of genetically normal HSC engraftment: Group 1 (transplanted with β-thalassemic BM alone; n = 8), 0%; group 2, 10.0%; group 3, 19.9%; group 4, 30.2%; group 5, 46.2%; and group 6, 100%. Group 7 (n = 5) represents a cohort of mice transplanted with 100% genetically normal Ly-5.1 BM cells. The data represent the mean and SEM of Hb concentration for each group. Groups 2 through 7 all differ significantly in Hb from group 1 (Pat least < .003). Groups 5, 6, and 7 did not significantly differ from one another (P > .25).
Amplification of the normal erythroid component appeared to occur late in erythropoiesis since the proportion of Ly-5.1+(CD45.1+)/TER119+cells, which define early erythroblasts derived from Ly-5.1 HSCs, in BM and spleen was equivalent to the proportion of Ly-5.1+ PB lymphocytes (data not shown). Also noteworthy was that 2 different cohorts of animals (groups 6 and 7) that received 100% genetically normal HSCs remained slightly anemic post-transplantation compared with non-transplanted controls (Table 1), establishing that complete correction in these experiments was reflected by a mean Hb concentration of 12.1 g/dL. Coincident with the increased Hb in the chimeric mice, reticulocyte counts, which averaged 21% in recipients that received only thalassemic marrow, decreased in proportion to the improvements in Hb concentration (Table 1). Additionally, splenic weights, reflecting extramedullary hematopoiesis, were significantly decreased in all chimeric animals, even those with only 10% normal HSC engraftment (Table 1).
Relationship between the level of human globin transgene expression and correction of the β-thalassemic phenotype
We crossed 2 strains of mice expressing an hγ-globin transgene at different levels with the β-thalassemic animals.37,38Resulting animals, which were heterozygous for both the hγ-globin transgene and the βthal knockout allele, expressed γ-globin mRNA at 3% (Figure 4A, lanes 2 and 3; strain A) or 7% (lanes 4 and 5; strain B) of the level of total mα-globin mRNA, as assessed by RNase protection assays. Interbreeding strain B resulted in the derivation of mice heterozygous for the βthal knockout allele and homozygous for the γ-globin transgene (strain C). Reticulocytes from these mice had a higher level of γ-globin mRNA expression (Figure 4A, lanes 6 and 7). In these animals, hγ-globin mRNA was 13% that of mα-globin mRNA. Interestingly, no β-thalassemic homozygotes containing γ-globin transgenes were recovered in these matings (0 of 49 pups; β-thalassemic homozygote with 13% γ-globin level: expected rate of 1 per 16 births). Mice doubly heterozygous for the βthalknockout allele and an hβ-globin locus YAC transgene39(strain D) were also derived. In this strain, the amount of human β mRNA relative to mouse α mRNA was 38% (Figure 4B).
Human globin transgene mRNA levels in the reticulocytes of β-thalassemic/β-globin transgenic animals.
(A) RNase protection assay using 250 ng RNA and probes for hγ-globin (exon 2) and mα-globin (exon 1). RNA samples obtained from the PB of the following animals were assayed in the same reaction for the amount of each globin mRNA: Lane 1: β-thalassemic littermate without a human globin transgene; lanes 2 and 3: β-thalassemic animals with an ankyrin promoter–γ-globin transgene (strain A); lanes 4 and 5: β-thalassemic animals with a β-spectrin promoter–γ-globin transgene (strain B); lanes 6 and 7: β-thalassemic animals homozygous for the β-spectrin promoter–γ-globin transgene (strain C). The sizes of the protected fragments (indicated by the arrows) are 225 bp for γ-globin and 128 bp for α-globin. (B) RNase protection assay using 250 ng and probes for hβ-globin (exon 1) and mα-globin (exon 1). RNA samples from 2 β-thalassemic animals containing the hβ-globin locus YAC28 (strain D) were assayed for the amount of hβ-globin and mα-globin in separate reactions owing to the similar sizes of the protected fragments for each transcript (135 bp and 128 bp, respectively).
Human globin transgene mRNA levels in the reticulocytes of β-thalassemic/β-globin transgenic animals.
(A) RNase protection assay using 250 ng RNA and probes for hγ-globin (exon 2) and mα-globin (exon 1). RNA samples obtained from the PB of the following animals were assayed in the same reaction for the amount of each globin mRNA: Lane 1: β-thalassemic littermate without a human globin transgene; lanes 2 and 3: β-thalassemic animals with an ankyrin promoter–γ-globin transgene (strain A); lanes 4 and 5: β-thalassemic animals with a β-spectrin promoter–γ-globin transgene (strain B); lanes 6 and 7: β-thalassemic animals homozygous for the β-spectrin promoter–γ-globin transgene (strain C). The sizes of the protected fragments (indicated by the arrows) are 225 bp for γ-globin and 128 bp for α-globin. (B) RNase protection assay using 250 ng and probes for hβ-globin (exon 1) and mα-globin (exon 1). RNA samples from 2 β-thalassemic animals containing the hβ-globin locus YAC28 (strain D) were assayed for the amount of hβ-globin and mα-globin in separate reactions owing to the similar sizes of the protected fragments for each transcript (135 bp and 128 bp, respectively).
We next determined whether the range of the levels of human globin mRNA in the various β-thalassemic mouse strains were reflected in the amounts of the derivative Hbs in red cells. Hb analysis proved that increasing γ-globin mRNA levels in strains A, B, and C were reflected by increasing amounts of a “fetal” Hb species, mα2hγ2 (Figure5). In strain A, mα2hγ2 was barely detectable on overexposed gels (lanes 3 through 5). However, in strain B erythrocytes, mα2hγ2 constituted an average of 13% of total Hb (lanes 6 through 8), while in strain C, mα2hγ2 composed an average of 27% of the total Hb (lanes 9 through 12). Strain D, expressing hβ-globin, had a high level (average, 38% of total Hb) of the Hb species, mα2hβ2, present in erythrocytes (lanes 12 through 14). FACS analysis of red cells from the various strains by means of monoclonal antibodies specific for Hb species containing either hγ-chains or hβ-chains demonstrated that in all the strains, the vast majority of red cells expressed the human globin transgenes (Figure 6). In addition, the increasing fluorescence intensity of the red cells for Hb species containing hγ-chains in strains A, B, and C paralleled their respective mRNA and Hb measurements (Figure 6A-C). Of interest was the presence of a subset of red cells having very high γ-globin content in strains A and B that overall expressed the hγ-globin transgene at relatively low levels (3% and 7%). This suggested a selection for cells stochastically having higher expression levels in these 2 strains.
Levels of human/murine chimeric Hb species in the red cells of β-thalassemic mice containing human globin transgenes.
Cellulose acetate Hb electrophoresis gels were used to separate the different Hb species as indicated by the arrows to the right. Lane 1 represents a sample from a normal mouse with the single Hb pattern in which mα2mβs2 and mα2mβt2 run together as a single band. Lane 2 represents a sample from a β-thalassemic mouse that has the diffuse Hb pattern, characterized by an uppermost mα2mβminor2 species and a faster migrating mα2mβmaj2species. Lanes 3 through 5 are samples from β-thalassemic mice with a human ankyrin promoter–γ-globin transgene (strain A); lanes 6 through 8 are samples from β-thalassemic mice with an hβ-spectrin promoter–γ-globin transgene (strain B); lanes 9 through 11 are samples from β-thalassemic mice that are homozygous for the β-spectrin promoter–γ-globin transgene; lanes 12 through 14 are samples from β-thalassemic mice with the hβ-globin locus YAC (strain D). The identities of the chimeric Hb species mα2hγ2 and mα2hβ2 at the indicated positions were previously confirmed independently by acid-urea gel electrophoresis.37
Levels of human/murine chimeric Hb species in the red cells of β-thalassemic mice containing human globin transgenes.
Cellulose acetate Hb electrophoresis gels were used to separate the different Hb species as indicated by the arrows to the right. Lane 1 represents a sample from a normal mouse with the single Hb pattern in which mα2mβs2 and mα2mβt2 run together as a single band. Lane 2 represents a sample from a β-thalassemic mouse that has the diffuse Hb pattern, characterized by an uppermost mα2mβminor2 species and a faster migrating mα2mβmaj2species. Lanes 3 through 5 are samples from β-thalassemic mice with a human ankyrin promoter–γ-globin transgene (strain A); lanes 6 through 8 are samples from β-thalassemic mice with an hβ-spectrin promoter–γ-globin transgene (strain B); lanes 9 through 11 are samples from β-thalassemic mice that are homozygous for the β-spectrin promoter–γ-globin transgene; lanes 12 through 14 are samples from β-thalassemic mice with the hβ-globin locus YAC (strain D). The identities of the chimeric Hb species mα2hγ2 and mα2hβ2 at the indicated positions were previously confirmed independently by acid-urea gel electrophoresis.37
FACS analysis for the presence of human globin chains in the red cells of β-thalassemic mice.
Red cells from strains A, B, and C (panels A-C) were stained for the presence of hγ-globin chains while red cells from strain D (panel D) were stained for the presence of hβ-globin chains. Histograms show the number of cells (x-axis), the PE fluorescence (y-axis) for each antibody stain, and the mean (x) fluorescence intensity value of the main population of positively staining cells.
FACS analysis for the presence of human globin chains in the red cells of β-thalassemic mice.
Red cells from strains A, B, and C (panels A-C) were stained for the presence of hγ-globin chains while red cells from strain D (panel D) were stained for the presence of hβ-globin chains. Histograms show the number of cells (x-axis), the PE fluorescence (y-axis) for each antibody stain, and the mean (x) fluorescence intensity value of the main population of positively staining cells.
Improvement in the Hb concentration (Figure7) and the red cell morphology and indices (Figure 8; Table2) and diminished reticulocytosis and splenic extramedullary erythropoiesis (as assessed by spleen weight) occurred in the strains expressing a human globin transgene. The level of human globin transgene expression, relative to the mα-globin, correlated with the amount of phenotypic correction. Interestingly, expression of hγ-globin mRNA at only 7% of mα mRNA (strain B) resulted in a greater than 2-g/dL increase in Hb concentration as well as improvements in the other measured parameters. Human γ-globin expression at 13% that of mα-globin resulted in nearly complete morphologic correction of red cells (Figure 8E) and a marked improvement in inefficient erythropoiesis (Table 2). These animals displayed only a slight hypochromic anemia. Perhaps surprisingly, even a slight, statistically significant improvement in the Hb was noted in strain A, in which hγ-globin gene expression was only 3% of the level of mα-globin mRNA.
The degree of correction of anemia in β-thalassemic animals as a function of the level of human globin transgene expression.
The PB Hb concentration is shown for each of the following strains of β-thalassemic animals characterized by the indicated ratios of hγ-globin/mα-globin mRNA: strain A (0.03; n = 11); strain B (0.07; n = 27); and strain C (0.13; n = 9). Strain D thalassemic animals (n = 7) have an hβ-globin/mα-globin mRNA ratio of 0.38. Hb concentrations for control littermate β-thalassemic (THAL; n = 24) and wild-type (WT; n = 52) animals are also shown. The data represent the mean and SEM of Hb concentration for each strain. Strain A differed significantly from THAL (P < .005), as did strains B, C, and D (P < .0001). Strain D and WT animals did not significantly differ in Hb concentration (P = .11).
The degree of correction of anemia in β-thalassemic animals as a function of the level of human globin transgene expression.
The PB Hb concentration is shown for each of the following strains of β-thalassemic animals characterized by the indicated ratios of hγ-globin/mα-globin mRNA: strain A (0.03; n = 11); strain B (0.07; n = 27); and strain C (0.13; n = 9). Strain D thalassemic animals (n = 7) have an hβ-globin/mα-globin mRNA ratio of 0.38. Hb concentrations for control littermate β-thalassemic (THAL; n = 24) and wild-type (WT; n = 52) animals are also shown. The data represent the mean and SEM of Hb concentration for each strain. Strain A differed significantly from THAL (P < .005), as did strains B, C, and D (P < .0001). Strain D and WT animals did not significantly differ in Hb concentration (P = .11).
Correction of β-thalassemic red cell morphologic abnormalities as a function of the level of human globin transgene expression.
Wright-Giemsa–stained PB smears from wild-type (panel A) and β-thalassemic (panel B) littermate controls are shown (250 × magnification) along with smears from strain A (panel C), strain B (panel D), strain C (panel E), and strain D (panel F).
Correction of β-thalassemic red cell morphologic abnormalities as a function of the level of human globin transgene expression.
Wright-Giemsa–stained PB smears from wild-type (panel A) and β-thalassemic (panel B) littermate controls are shown (250 × magnification) along with smears from strain A (panel C), strain B (panel D), strain C (panel E), and strain D (panel F).
Effects of human globin transgene expression on β-thalassemic erythropoiesis
| Mice . | Human globin/murine α† . | Hb, g/dL . | MCH, pg . | RDW . | Retic, % . | Spleen, mg . |
|---|---|---|---|---|---|---|
| THAL | NA | 9.13 ± 0.13 | 12.9 ± 0.27 | 33.3 ± 0.66 | 21.8 ± 1.5 | 392 ± 35 |
| Strain A | 0.03 | 9.77 ± 0.11* | 13.9 ± 0.47 | 31.0 ± 0.67* | 20.6 ± 1.3 | 406 ± 52 |
| Strain B | 0.07 | 11.2 ± 0.12* | 14.1 ± 0.31* | 29.6 ± 0.54* | 14.0 ± 1.3* | 208 ± 33* |
| Strain C | 0.13 | 12.4 ± 0.60* | 14.9 ± 0.44* | 24.5 ± 0.72* | 7.70 ± 1.4* | 125 ± 13* |
| Strain D | 0.38 | 13.9 ± 0.31* | 15.1 ± 0.26* | 19.2 ± 0.69* | 1.95 ± 0.22* | 113 ± 6* |
| WT | NA | 14.5 ± 0.13* | 16.7 ± 0.17* | 18.5 ± 0.20* | 1.75 ± 0.25* | 99 ± 8* |
| Mice . | Human globin/murine α† . | Hb, g/dL . | MCH, pg . | RDW . | Retic, % . | Spleen, mg . |
|---|---|---|---|---|---|---|
| THAL | NA | 9.13 ± 0.13 | 12.9 ± 0.27 | 33.3 ± 0.66 | 21.8 ± 1.5 | 392 ± 35 |
| Strain A | 0.03 | 9.77 ± 0.11* | 13.9 ± 0.47 | 31.0 ± 0.67* | 20.6 ± 1.3 | 406 ± 52 |
| Strain B | 0.07 | 11.2 ± 0.12* | 14.1 ± 0.31* | 29.6 ± 0.54* | 14.0 ± 1.3* | 208 ± 33* |
| Strain C | 0.13 | 12.4 ± 0.60* | 14.9 ± 0.44* | 24.5 ± 0.72* | 7.70 ± 1.4* | 125 ± 13* |
| Strain D | 0.38 | 13.9 ± 0.31* | 15.1 ± 0.26* | 19.2 ± 0.69* | 1.95 ± 0.22* | 113 ± 6* |
| WT | NA | 14.5 ± 0.13* | 16.7 ± 0.17* | 18.5 ± 0.20* | 1.75 ± 0.25* | 99 ± 8* |
Values represent the mean and SEM.
THAL indicates thalassemic; WT, wild type; Hb, hemoglobin; MCH, mean corpuscular hemoglobin; RDW, red cell distribution width; retic, reticulocyte; Spleen, splenic weight; NA, not applicable.
Statistically significant difference from THAL with P of at least < .006.
Ratio of human γ-globin (strains A, B, and C) or human β-globin (strain D) messenger RNA to total mouse α-globin messenger RNA.
Discussion
Using chimeric mice transplanted with defined mixtures of normal and β-thalassemic HSCs, we documented significant amplification of the erythroid lineage derived from the genetically normal HSC component. These data provide an accurate quantitative estimate of the relative contribution of genetically normal HSCs to the erythroid compartment in animals with predominantly β-thalassemic hematopoiesis and indicate that as much as a 5-fold amplification can be anticipated in the setting of β-thalassemia intermedia. Even thalassemic animals with relatively low levels of normal HSC chimerism displayed significant phenotypic improvement, as judged by a higher Hb level as well as other indices reflective of more effective erythropoiesis. These data suggest that while a normal or gene-corrected HSC chimerism level of 10% would have some clinical benefit, a chimerism level of 20% would have significant impact in patients with β-thalassemia intermedia and severe anemia.
Prior studies using a different β-thalassemic mouse strain had suggested that the erythroid component of a genetically normal hematopoietic graft is amplified. However, these studies did not provide a careful quantitative estimate of the degree of amplification in chimeric animals or define the degree of correction of the thalassemic phenotype as a function of the level of normal HSC chimerism.26-28 Early human transplantation trials for β-thalassemia major suggested a low but significant incidence of mixed chimerism in patients receiving a matched, allogeneic BM graft, although the incidence declined by the end of the first year post-transplant.30 Over the years, additional data from continuing transplantation studies documented that within this subset of transplant recipients, rare patients with long-term, persistent mixed chimerism characterized by fewer than 75% donor PB leukocytes are observed.32,33 Andreani et al33 reported on 11 patients who were transfusion independent with normal donor chimerism levels of less than 75%. Of these 11 patients, only 4 had chimerism levels lower than 50%, the lowest level observed being 25% in 2 β0-thalassemic patients who had untransfused Hb levels of 8.3 and 9.3 g/dL, respectively. Our data using a murine model of β-thalassemia intermedia expand upon these limited clinical observations and confirm that a significant, therapeutic amplification of a normal or gene-corrected erythroid component occurs with normal HSC chimerism levels as low as 10% to 20%. Furthermore, although we observe some hematologic improvement in this murine model of β-thalassemia intermedia with normal HSC chimerism as low as 10%, this level of chimerism may have greater impact in the setting of β0-thalassemia. This hypothesis is being directly evaluated by using mixtures of fetal liver HSCs from genetically normal embryos and β0-thalassemic embryos, which are homozygous for the knockout allele, to generate cohorts of chimeric mice similar to those in this report.
Of interest is that the amelioration of anemia by relatively low levels of normal HSC chimerism, both in our studies and in the patient data cited above, is incomplete despite the majority of the circulating red cells being derived from the genetically normal component of the BM graft (Figures 1-3). We infer from these observations that the erythropoietic stimulus that occurs as a consequence of anemia acts equally on early thalassemic and normal erythroid progenitors, without preferential amplification of normal cells at this level in erythropoiesis. Indeed, FACS analysis indicated that the proportion of both splenic and BM genetically normal early erythroblasts relative to thalassemic erythroblasts, characterized by TER119 and CD45 double positivity, is not amplified but rather parallels the proportion observed for normal PB lymphocytes relative to thalassemic lymphocytes. This is consistent with the findings of Adreani et al,33which showed a lack of amplification of normal donor burst-forming units–erythroid relative to BM or PB normal donor leukocytes in 4 patients with low-level donor chimerism.
Together, these observations indicate that amplification of the genetically normal erythroid component occurs late, beyond the pro-erythroblast/basophilic erythroblast stage and after the erythroid compartment is established. Amplification probably occurs because erythropoiesis by the genetically normal erythroid component is more effective than the β-thalassemic component in the latter stages of erythropoiesis (when globin chain imbalance develops, leading to α-globin chain precipitation)47 and survival of the red cells generated by the normal component is significantly longer.48 However, the total output of red cells from the normal subset of erythroblasts is presumably limited by their absolute mass and the number of cell divisions that occur during the final stages of erythroid maturation. Additionally, it is uncertain what influence the persistence of thalassemic erythroid cells may have on the development of the normal erythroid component, either directly or through perturbations of the local cellular microenvironment.
In a second, independent set of experiments using transgenic mouse strains, we established that relatively low levels of expression of a γ-globin transgene improves the β-thalassemic phenotype. Our results are consistent with recently published work in which a lentiviral vector was used to insert a β-globin gene with regulatory elements into the stem cells of a similar strain of mice with β-thalassemia intermedia.22 In this work, the globin vector was present in a majority of the transplanted BM cells, and the β-globin transgene was expressed in most of the red cells at an overall level of about 17% that of one β-globin gene (approximately 9% of the output of a full complement of normal globin genes, which compares to the results of our study). Our data are also consistent with observations in patients with β-thalassemia who have a relatively mild phenotype because of co-inheritance of genetic determinants that increase γ-globin synthesis.1,3Specific γ-globin–promoter mutations that are associated with hereditary persistence of fetal Hb in otherwise normal individuals, when co-inherited with a β-thalassemia mutation, result in a striking amelioration of the disease manifestations.1,3Additionally, genetic determinants associated with the XmnI polymorphism, which in normal individuals do not result in an increase in HbF, when co-inherited with homozygous β-thalassemia are associated with a milder thalassemia phenotype.49
However, data on these types of patients have been limited to documenting the accumulated level of fetal Hb in the PB, which is known to grossly misrepresent the actual production of γ-globin chains in BM precursors.50 Careful analysis of the relative γ-globin mRNA levels that resulted in the milder disease phenotype in these patients was not done. Therefore, it is difficult to extrapolate from these previous studies the level of mRNA from a transferred globin gene that would be needed in developing β-thalassemic erythroblasts in order to achieve a therapeutic effect. Our data predict that a relative γ-globin mRNA level of 7% and higher would have significant impact on β-thalassemia intermedia.
Application of gene therapy approaches for the treatment of severe β-thalassemia is likely to occur initially in the context of minimal myeloablation. Treated individuals are therefore likely to have a mixture of a small minority of genetically modified autologous cells, in which vector-mediated globin transgene expression is significantly less than the output of the normal hβ-globin gene locus, in a background majority of unmodified, diseased cells. Recent improvements in globin vectors have led to globin transgene expression approaching 10% of the level of endogenous α-globin,21,22 close to the value (13%) that we estimate gives nearly complete correction of the red cell abnormalities in β-thalassemia intermedia. Despite these improvements in vector-mediated globin expression, a clinical benefit will require significant levels of gene-corrected cell chimerism, on the order of at least 10% to 20% by our estimates. Given current human HSC gene transfer efficiencies and the likelihood of minimally conditioned recipients, an in vivo selection strategy, such as that based on positive selection or through the use of cis-linked drug resistance genes, will be required.51-55
Previous work has demonstrated the ability of systems based on expression of variant forms of dihydrofolate reductase or methylguanine methyltransferase (MGMT) to select for genetically modified murine HSCs.52-54 In addition, we have recently obtained data documenting a significant therapeutic benefit by amplifying subtherapeutic, low levels of genetically normal cells in β-thalassemic mice using the MGMT system.55 Although these data are encouraging, successful in vivo selection in larger animals and humans has yet to be reported. However, it seems probable that an optimized globin vector will require incorporation of a selectable marker gene to provide for the selection and amplification of gene-corrected cells.
Individuals who are doubly heterozygous for the HbE mutation and a β-thalassemia mutation and some who are compound heterozygotes for 2 different thalassemia mutations have severe anemia and complications arising from iron overload but may require only intermittent transfusions.1,3 The β-thalassemia intermedia phenotype in these individuals is in many respects comparable to that observed in the mβ-globin locus knockout models.35,36 Such individuals might be appropriate initial participants in a gene therapy trial designed to achieve a significant but minority population of genetically modified cells. The data presented here suggest that a clinical improvement in these individuals would be observed if 20% of the HSCs contained a transferred gene that, in the erythroid lineage, was expressed at 15% or higher of the level of the normal α- or β-globin gene loci. Alternatively, a meaningful therapeutic impact would be predicted if a nonmyeloablative, allogeneic mini-transplant approach could achieve stable, low levels of normal donor chimerism of about 20% in the absence of significant toxicity.56 57Both of these approaches merit consideration as alternative therapeutic strategies for the treatment of the more severe forms of β-thalassemia intermedia. The impact of achieving these parameters in patients with β0-thalassemia is not immediately clear, but the limited clinical data predict a therapeutic effect.
The authors thank Dr Ann Marie Hamilton-Easton and Ed Wingfield in the flow cytometry laboratory of Dr Richard Ashmun for their expert technical help in FACS analyses; Cynthia Gander for expertise in breeding the transgenic and knockout animals; Drs B. Sorrentino, P. Ney, and J. Cunningham for critical review of this manuscript; Elizabeth Barnes and Phillip Hargrove for their expert technical assistance; and Jean Johnson for help with manuscript preparation.
Supported by the National Heart, Lung, and Blood Institute (NHLBI) Program Project grant P01 HL 53749 (A.W.N.), the NHLBI grant K08 HL04205-01 (D.A.P.), a Cancer Center Support Grant, and the American Lebanese Syrian Associated Charities.
The publication costs of this article were defrayed in part by page charge payment. Therefore, and solely to indicate this fact, this article is hereby marked “advertisement” in accordance with 18 U.S.C. section 1734.
References
Author notes
Derek A. Persons, 332 North Lauderdale, Division of Experimental Hematology, St Jude Children's Research Hospital, Memphis, TN 38105; e-mail: derek.persons@stjude.org.

This feature is available to Subscribers Only
Sign In or Create an Account Close Modal